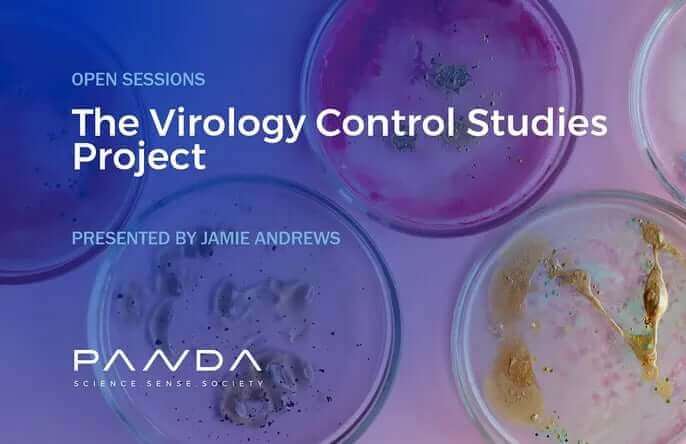
Interview on the results of the Control Studies Experiments with Pandata

Challenging Science: PETER AND PETE x Virology Control INTERVIEW
Virology Control Studies: Jamie Andrews

Virology Control Studies: Jamie Andrews

Virology Control Studies: Jamie Andrews
Virology Control Studies: Jamie Andrews

Virology Control Studies: Jamie Andrews

Virology Control Studies: Jamie Andrews

Virology Control Studies: Jamie Andrews

Virology Control Studies: Jamie Andrews

Virology Control Studies: Jamie Andrews